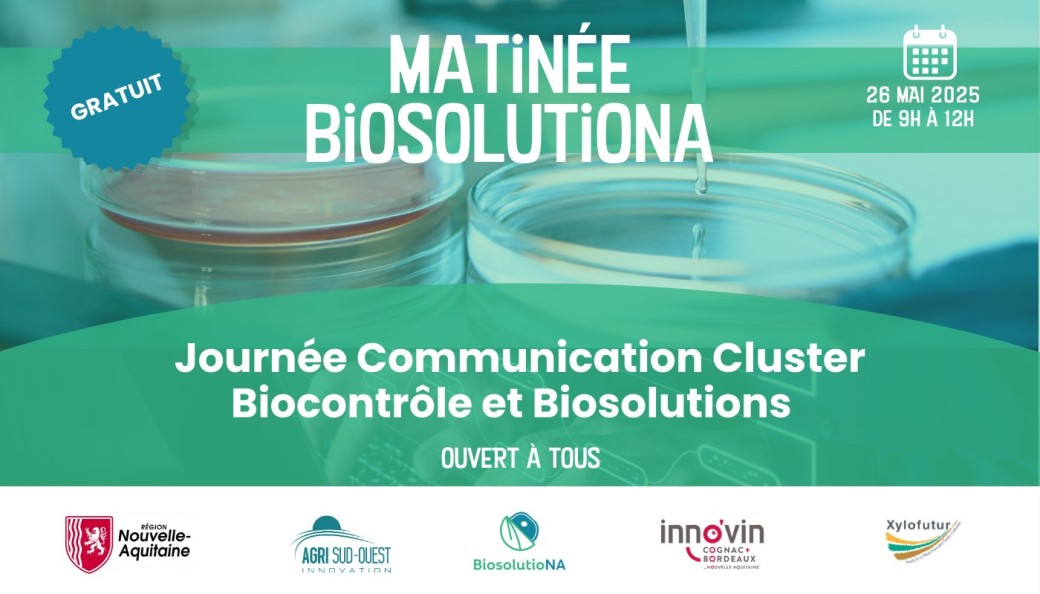

Biosolutions & Biocontrôle Réinventer l’Agriculture Ensemble
Mon May 26, 2025 from 08:30 AM to 03:00 PM
Timezone : Europe/Paris
Parc des Expositions de Bordeaux, Cours Jules Ladoumegue, Bordeaux, France
Date and place
Mon May 26, 2025 from 08:30 AM to 03:00 PM
Timezone : Europe/Paris
